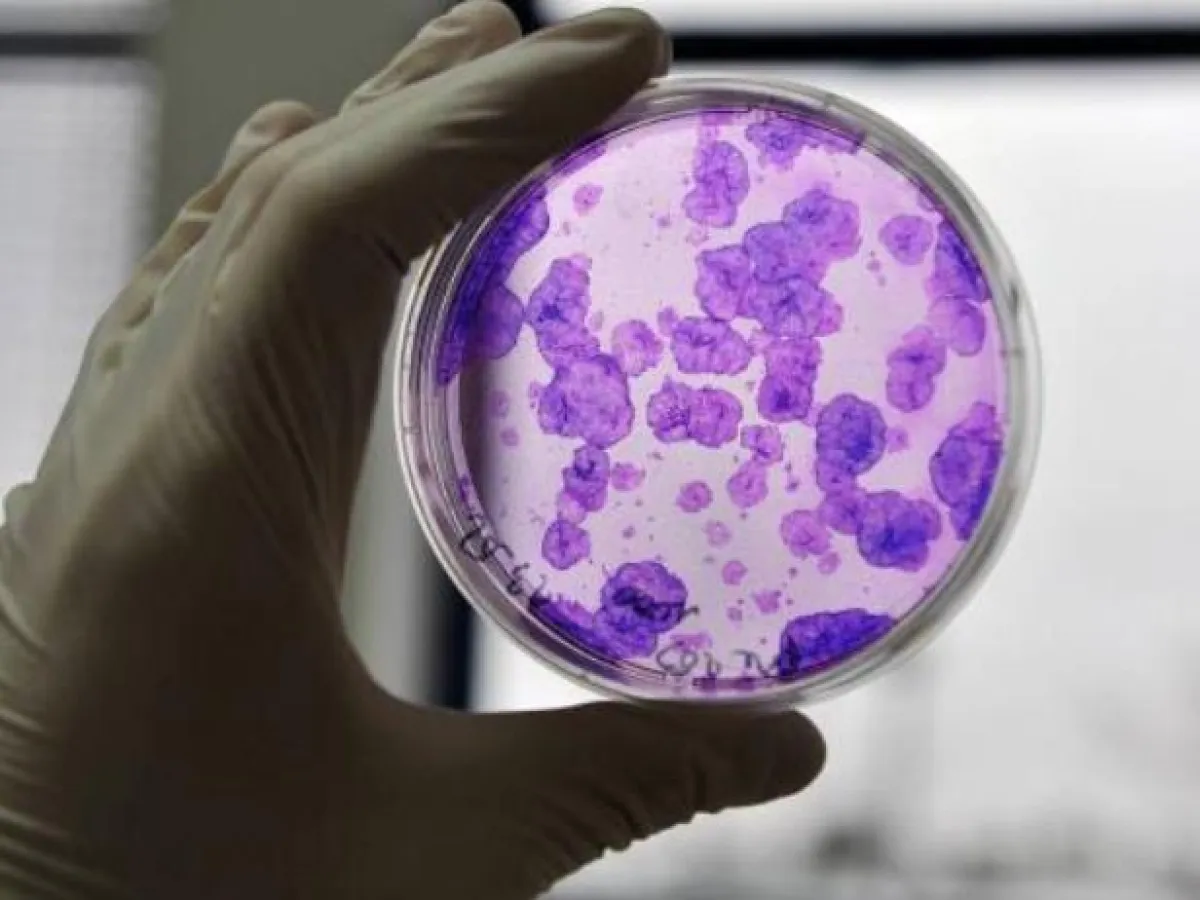

يؤثّر ضعف الانتصاب على قرابة نصف الرجال الذين تتراوح أعمارهم بين 40 _ 70 عاماً. وثمّة أسباب كثيرة لهذه المشكلة، منها الخضوع لجراحة البروستات، وضغط الدم العالي، والسكري، وأمراض القلب والأوعية الدمويّة، والاضطرابات النفسيّة المختلفة.
قد تكون الخلايا الجذعيّة حلاً علاجيّاً مناسباً لمعالجة مشاكل الانتصاب، وذلك بحسب نتائج دراسة تمَّ تقديمها في لندن، خلال مؤتمر الجمعيّة الأوروبيّة لجراحة المسالك البوليّة (EAU).
والعلاجات الحاليّة مثل الأدوية التي تشمل الفياغرا والسياليس، والحُقن أو زراعة القضيب، تُحدث جميعها أثاراً سلبيّة غير مريحة. ويسعى العلماء إلى إيجاد حلّ يعيد الأداء الجنسي للرجل بطريقة طبيعيّة.
الخلايا الجذعية: فعاليّة للمدى البعيد
أجرى الباحثون في مستشفى جامعة "أودنسي" في الدنمارك، هذه الدراسة على 21 مريضاً يعانون مشاكل أو ضعفاً في الانتصاب، بعد خضوعهم لعمليّات جراحيّة لاستئصال البروستات، والتي أُجريت كجزء من علاج مرض سرطان البروستات.
وقد استخدم الباحثون الخلايا الجذعيّة المأخوذة من الخلايا الدهنيّة في البطن، عن طريق عمليّة شفط الدهون. وبعد عزل الخلايا الجذعيّة من تلك الخلايا، قاموا بحقنها في المنطقة الغائرة من الجسم الكهفي للقضيب. ولم يبلَّغ أيّ من الـــ21 رجلاً عن أيّ آثار جانبيّة سلبيّة مهمّة خلال الفترة التجريبيّة، أو طوال العام التالي للعمليّة.
في غضون 6 أشهر من العلاج، قال 8 من أصل 21 رجلاً تحت العلاج، إنّهم تعافوا من ضعف الانتصاب بشكل يكفي لتحقيق الرضا في النشاط الجنسي. واستمر هذا التحسن لمدّة عام واحد، ما يشير إلى أنّ هذا العلاج قد يجلب فوائد طويلة الأمد.
"إنّها المرة الأولى التي يسمح بها العلاج بواسطة الخلايا الجذعيّة للمرضى، بالتعافي من ضعف الانتصاب بشكل يكفي لممارسة الجنس"، بحسب ما يوضح د. مارثا هاهر.
ويضيف: "نحن بشكل عام راضون عن النتائج الأوليّة، وخصوصاً أنَّ هؤلاء الرجال لم يلمسوا أيّ تحسن بعد العلاج بالأدوية التقليديّة في السابق، واستمر أداء وظيفة الانتصاب بشكل جيد بعد 12 شهراً من المتابعة، الأمر الذي يشير إلى أنَّ هذا الحل قد يكون طويل الأمد، ولكن رغم ذلك علينا أن نتذكر، أنّ هذه مجرد تجربة بسيطة، ومن دون أن تكون هناك مجموعة سيطرة خلال العمل، وما زلنا بعيدين عن إيجاد حلّ على المستوى السريري".

Google News
Google News 




















